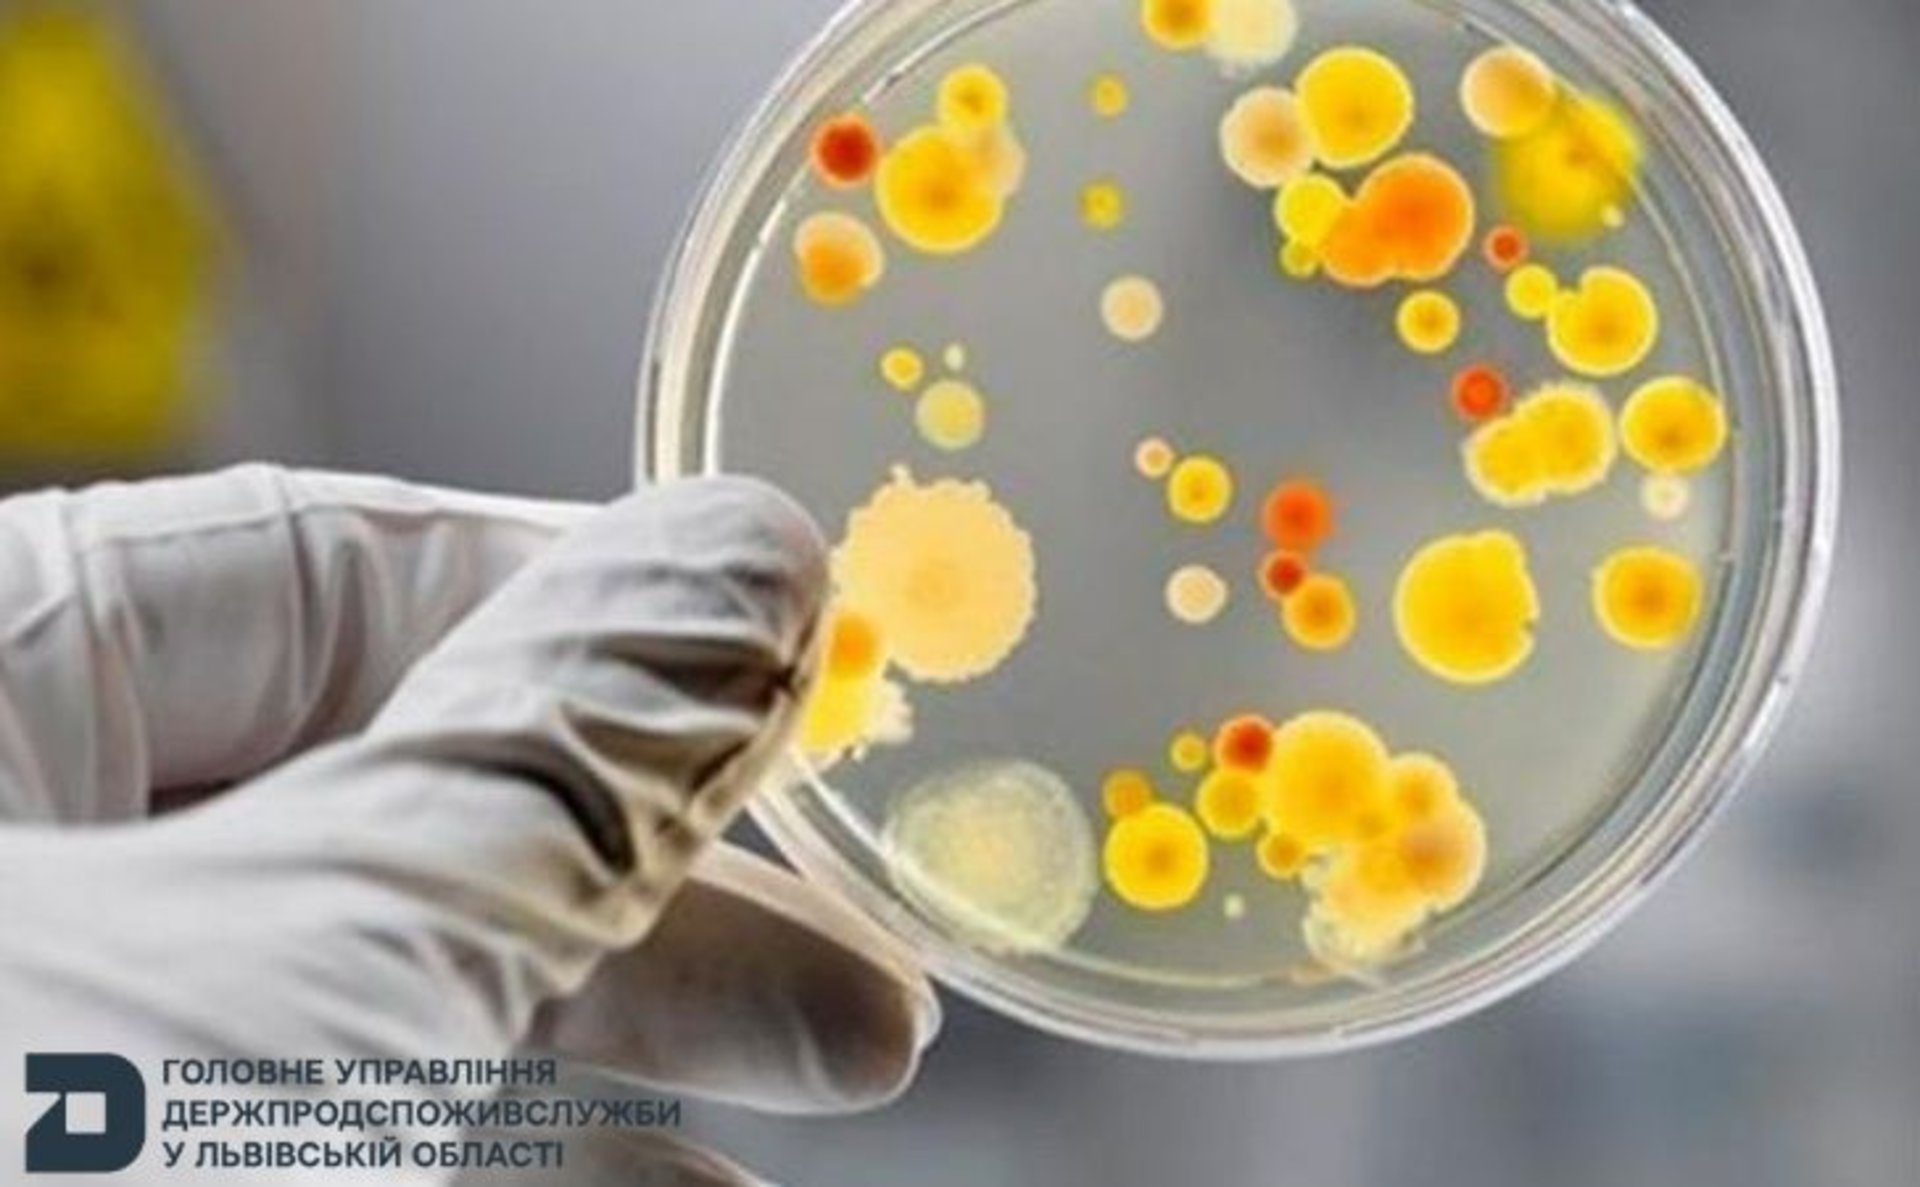

Зросла кількість постраждалих від спалаху кишкової інфекції у відпочинковому таборі на Львівщині (ВІДЕО)
З первинним діагнозом «гостра кишкова інфекція» вже госпіталізовано 32 особи
У відпочинковому таборі «Friendli Camp», розташованому в селі Тухля Стрийського району Львівської області, зафіксовано спалах гострої кишкової інфекції.
Як повідомляє Головне управління Держпродспоживслужби у Львівській області, станом на 05.08.2025 з первинним діагнозом «гостра кишкова інфекція» госпіталізовано 32 особи.
Читайте також: На Львівщині сталося масове отруєння у дитячому таборі
Спеціалісти Головного управління Держпродспоживслужби у Львівській області спільно з працівниками ДУ «Львівський обласний центр контролю та профілактики хвороб МОЗ України» проводять епідеміологічне розслідування для з’ясування джерела інфекції, причин та умов виникнення спалаху. Епідрозслідування триває.

varta1.com.ua: Новини
Читайте також

У пʼятницю Львів попрощається із захисниками Віталієм Калімуліним та Романом Чайкою
Львів попрощається з військовослужбовцями Віталієм Калімуліним та Романом Чайкою, які віддали життя, захищаючи Україну від російських окупантів

На Львівщині висадили гектар лісу в пам’ять про полеглого воїна-лісівника Андрія Позняка
Акція «Ліси пам’яті» об’єднала рідних захисника, колег та громаду заради вшанування подвигу героя

На Львівщині під час пожежі сухостою у дачному кооперативі загинув чоловік
Трагедія сталася через займання сухої трави на території дачного кооперативу у селі Межиріччя
Найкоментованіше
- У Львові відбувся протест проти "Аксіома Медікал" (ВІДЕО)
- Підтверджено загибель Героя зі Львівщини, який з 2025 року вважався безвісти зниклим
- Сокільники збудують власні сучасні очисні споруди та позбудуться інфраструктурної залежності
- Мінекономіки ускладнило вимоги для бізнесу щодо бронювань працівників
- Навроцького не запросили на конференцію щодо України в Гданську, де будуть Туск і Зеленський
Найчитаніше
- На Львівщині юнак вбив маму та скоїв смертельну ДТП (ФОТО, ВІДЕО)
- Увага! У Львові розшукується безвісти зниклі мама та син
- Опубліковано відео моменту ДТП з перекиданням авто у Львові
- Підтверджено загибель Героя зі Львівщини, який з 2025 року вважався безвісти зниклим
- У Тернополі у міському ставі потонула 15-річна дівчина


Коментарі